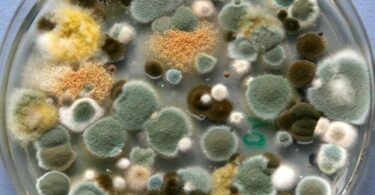

Плесень может появиться в любой квартире. Она далеко не всегда спутник неухоженных домов. Едва споры грибка попадают в благоприятные условия, как тут же начинают размножаться. Если не принять вовремя меры по уничтожению плесени, она испортит...
Плесень
Как избавиться от плесени и затхлого запаха в шкафу
Чаще всего плесень появляется в ванной комнате, туалете и на кухне, но иногда грибок можно обнаружить в шкафу. Это приводит не только к неприятному запаху, исходящему от вещей, их порче, но и может способствовать развитию серьезных заболеваний у...
Оптимальная влажность и температура и способы их регулирования
Чтобы хорошо себя чувствовать, нужно следить за микроклиматом в квартире. Заметные отклонения от рекомендованных значений влажности и температуры воздуха сказываются на самочувствии, работоспособности, приводят к проблемам со здоровьем. Что...
Виды, состав и свойства плесени
Каждый человек не единожды видел плесень. Это мог быть зеленоватый налет на залежавшемся куске хлеба, белый пушок на земле в цветочном горшке, темно-серые пятна на протекшем потолке или на кафельной плитке в ванной комнате. Существует огромное...
Как убрать запах плесени и сырости
Как пахнет плесень в квартире известно многим людям, этот запах вряд ли можно спутать с чем-нибудь. Но он не только вызывает неприятные ощущения, но и сигнализирует о развитии грибка, который представляет опасность для всех жильцов дома, поскольку...
Плесень на соленых и маринованных грибах
Соленые и маринованные грибы – вкусные и очень популярные закуски. Многие хозяйки по осени делают заготовки из даров леса, а зимой подают к столу, радуя домочадцев и гостей. Но довольно часто в открытой банке обнаруживается плесневой налет. Не стоит...
Опасность появления плесени в доме
С плесенью хотя бы раз сталкивался абсолютно каждый. Это могли быть небольшие белые пятнышки на полежавшем куске хлеба, зеленый налет на овощах, черные пятна на кафеле в ванной или на сырой стене подвала. Вряд ли найдется человек, не знающий о том...
Как избавиться от плесени в ванной комнате
Темно-серый налет на потолке и стенах ванной комнаты, черные швы между плитками, гнилостный запах – все это признаки появления грибка. Плесень – это не только не эстетично, но и опасно для здоровья. Избавляться от нее надо сразу же, едва заметив...